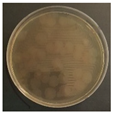
Ijerph 19 09659 i003
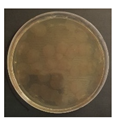
Ijerph 19 09659 i005
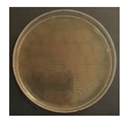
Ijerph 19 09659 i007
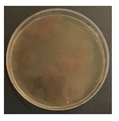
Ijerph 19 09659 i011
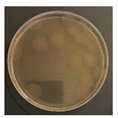
Ijerph 19 09659 i014
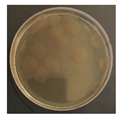
Ijerph 19 09659 i015
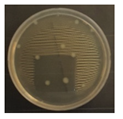
Ijerph 19 09659 i016
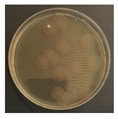
Ijerph 19 09659 i018
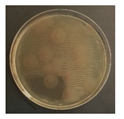
Ijerph 19 09659 i019
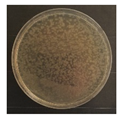
Ijerph 19 09659 i020
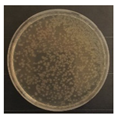
Ijerph 19 09659 i023
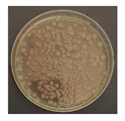
Ijerph 19 09659 i024
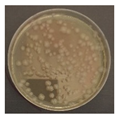
Ijerph 19 09659 i026
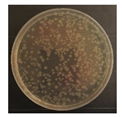
Ijerph 19 09659 i027
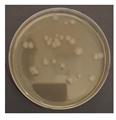
Ijerph 19 09659 i030
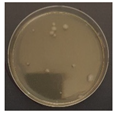
Ijerph 19 09659 i032
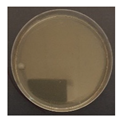
Ijerph 19 09659 i033
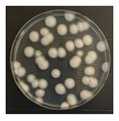
Ijerph 19 09659 i039
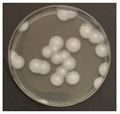
Ijerph 19 09659 i040
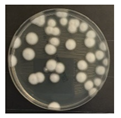
Ijerph 19 09659 i042
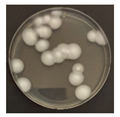
Ijerph 19 09659 i044
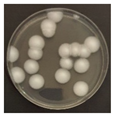
Ijerph 19 09659 i045
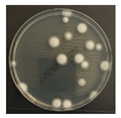
Ijerph 19 09659 i046
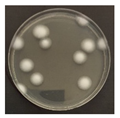
Ijerph 19 09659 i052
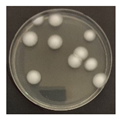
Ijerph 19 09659 i053
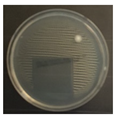
Ijerph 19 09659 i054
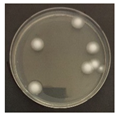
Ijerph 19 09659 i057
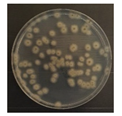
Ijerph 19 09659 i058
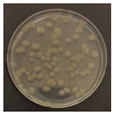
Ijerph 19 09659 i060
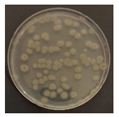
Ijerph 19 09659 i063
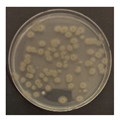
Ijerph 19 09659 i064
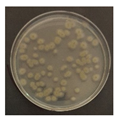
Ijerph 19 09659 i066
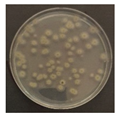
Ijerph 19 09659 i067
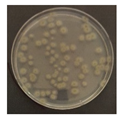
Ijerph 19 09659 i068
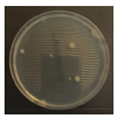
Ijerph 19 09659 i069
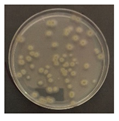
Ijerph 19 09659 i070
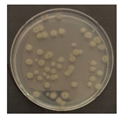
Ijerph 19 09659 i072
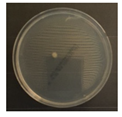
Ijerph 19 09659 i073
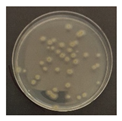
Ijerph 19 09659 i075

The Wavelength-Based Inactivation Effects of a Light-Emitting Diode Module on Indoor Microorganisms
Abstract
1. Introduction
2. Materials and Methods
2.1. LED Module
2.2. Microorganisms
2.3. Experiment Setup
2.4. Survival Rate
3. Results
3.1. Thermal Conditions
3.2. Inactivation Effect
3.2.1. Reduction Rate
3.2.2. Sterilization Coefficient, k
3.3. Comparing Energy Consumption
4. Discussion
5. Conclusions
- (1)
- The sterilization effect at 405 nm was inferior to that of UV-C sterilization. However, when compared with the sterilization effects of 370 and 385 nm in the near-UV range, this difference was insignificant.
- (2)
- Visible light sterilization required long-term irradiation to achieve its purpose. However, since visible light can be used in a general living environment, it could be expected that direct sterilization would be possible in spaces where people live through the application of general lighting. However, it is necessary to proceed with research on the safety of 405 nm. Therefore, the application of the visible light wavelength to the general environment should be considered for an appropriate range.
- (3)
- In terms of energy consumption, no significant difference was observed between the sterilization using visible light and that using UV-A wavelengths. The power consumed when using the LED module for the time required to sterilize 99.9% of each microorganism was compared. The results showed that the sterilization effect and power consumption of 405 nm were similar to or less than those at 385 nm. This had a significant impact owing to the differences in the module output; however, when visible light sterilization was used, its development value remained high if its output was considered.
- (4)
- In terms of the sterilization of microorganisms, research has been conducted in the fields of biology, food, and medicine, and the process can be of great value for commercial use. Considering the safety of visible light, it can be a means of countering infectious diseases in engineering buildings, including private and public spaces where people spend most of their time.
Author Contributions
Funding
Institutional Review Board Statement
Informed Consent Statement
Data Availability Statement
Conflicts of Interest
References
- Morawsk, L.; Tang, J.W.; Bahnfleth, W.; Bluyssen, P.M.; Boerstra, A.; Buonanno, G.; Gao, J.; Dancer, S.; Floto, A.; Yao, M.; et al. How can airborne transmission of COVID-19 indoors be minimised? Environ. Int. 2020, 142, 105832. [Google Scholar] [CrossRef] [PubMed]
- Godri Pollitt, K.J.; Peccia, J.; Ko, A.I.; Kaminski, N.; Dela Cruz, C.S.; Nebert, D.W.; Rerchardt, J.K.V.; Thompson, D.C.; Vasiliou, V. COVID-19 vulnerability: The potential impact of genetic susceptibility and airborne transmission. Hum. Genom. 2020, 14, 1–7. [Google Scholar] [CrossRef] [PubMed]
- Kowalski, W. Ultraviolet Germicidal Irradiation Handbook: UVGI for Air and Surface Disinfection; Springer Science & Business Media: Berlin, Germany, 2010. [Google Scholar] [CrossRef]
- Sung, M.; Kato, S. Estimating the germicidal effect of upper-room UVGI system on exhaled air of patients based on ventilation efficiency. Build. Environ. 2011, 46, 2326–2332. [Google Scholar] [CrossRef] [PubMed]
- Bang, J.I.; Park, J.; Choi, A.; Jeong, J.W.; Kim, J.Y.; Sung, M. Evaluation of UR-UVGI system for sterilization effect on microorganism contamination in negative pressure isolation ward. Sustainability 2018, 10, 3192. [Google Scholar] [CrossRef]
- Sung, M.; Kato, S.; Yanagi, U.; Kim, M.; Harada, M. Disinfection performance of ultraviolet germicidal irradiation systems for the microbial contamination on an evaporative humidifier. HVACR Res. 2011, 17, 22–30. [Google Scholar] [CrossRef]
- Bang, J.I.; Park, J.Y.; Jo, Y.L.; Jeong, J.W.; Choi, A.; Sung, M. Sterilization effectiveness of in-duct ultraviolet germicidal irradiation system in liquid desiccant and indirect/direct evaporative cooling-assisted 100% outdoor air system. Build. Environ. 2020, 186, 107350. [Google Scholar] [CrossRef]
- Muramoto, Y.; Kimura, M.; Nouda, S. Development and future of ultraviolet light-emitting diodes: UV-LED will replace the UV lamp. Semicond. Sci. Technol. 2014, 29, 084004. [Google Scholar] [CrossRef]
- Malik, S.A.; Swee, T.T.; Malek, N.A.N.N.; Kadir, M.R.A.; Emoto, T.; Akutagawa, M.; Meng, L.K.; Hou, T.J.; Alang, T.A.I.T. Comparison of standard light-emitting diode (LED) and 385 nm ultraviolet A LED (UVA-LED) for disinfection of Escherichia coli. Malays. J. Fundam. Appl. Sci. 2017, 13, 430–437. [Google Scholar] [CrossRef][Green Version]
- Kim, D.K.; Kang, D.H. UVC LED irradiation effectively inactivates aerosolized viruses, bacteria, and fungi in a chamber-type air disinfection system. Appl. Environ. Microbiol. 2018, 84, e00944–e00918. [Google Scholar] [CrossRef]
- Lai, A.C.; Nunayon, S.S. A new UVC-LED system for disinfection of pathogens generated by toilet flushing. Indoor Air 2021, 31, 324–334. [Google Scholar] [CrossRef]
- Nunayon, S.S.; Zhang, H.; Lai, A.C. Comparison of disinfection performance of UVC-LED and conventional upper-room UVGI system. Indoor Air 2020, 30, 180–191. [Google Scholar] [CrossRef] [PubMed]
- Murdoch, L.E.; Maclean, M.; MacGregor, S.J.; Anderson, J.G. Inactivation of Campylobacter jejuni by exposure to high-intensity 405-nm visible light. Foodborne Pathog. Dis. 2010, 7, 1211–1216. [Google Scholar] [CrossRef] [PubMed]
- Sommers, C.; Gunther IV, N.W.; Sheen, S. Inactivation of Salmonella spp., pathogenic Escherichia coli, Staphylococcus spp., or Listeria monocytogenes in chicken purge or skin using a 405-nm LED array. Food Microbiol. 2017, 64, 135–138. [Google Scholar] [CrossRef]
- Murdoch, L.E.; Maclean, M.; Endarko, E.; MacGregor, S.J.; Anderson, J.G. Bactericidal effects of 405 nm light exposure demonstrated by inactivation of Escherichia, Salmonella, Shigella, Listeria, and Mycobacterium species in liquid suspensions and on exposed surface. Sci. World J. 2012, 2012, 8. [Google Scholar] [CrossRef] [PubMed]
- De Santis, R.; Luca, V.; Faggioni, G.; Fillo, S.; Stefanelli, P.; Rezza, G.; Lista, F. Rapid inactivation of SARS-CoV-2 with LED irradiation of visible spectrum wavelengths. medRxiv 2020, 8, 100082. [Google Scholar] [CrossRef]
- Endarko, E.; Maclean, M.; Timoshkin, I.V.; MacGregor, S.J.; Anderson, J.G. High-intensity 405 nm light inactivation of Listeria monocytogenes. Photochem. Photobiol. 2012, 88, 1280–1286. [Google Scholar] [CrossRef]
- Li, X.; Kim, M.J.; Bang, W.S.; Yuk, H.G. Anti-biofilm effect of 405-nm LEDs against Listeria monocytogenes in simulated ready-to-eat fresh salmon storage conditions. Food Control 2018, 84, 513–521. [Google Scholar] [CrossRef]
- Kumar, A.; Ghate, V.; Kim, M.J.; Zhou, W.; Khoo, G.H.; Yuk, H.G. Kinetics of bacterial inactivation by 405 nm and 520 nm light emitting diodes and the role of endogenous coproporphyrin on bacterial susceptibility. J. Photochem. Photobiol. B Biol. 2015, 149, 37–44. [Google Scholar] [CrossRef]
- Sklar, L.R.; Almutawa, F.; Lim, H.W.; Hamzavi, I. Effects of ultraviolet radiation, visible light, and infrared radiation on erythema and pigmentation: A review. Photochem. Photobiol. Sci. 2012, 12, 54–64. [Google Scholar] [CrossRef]
- Guffey, J.S.; Wilborn, J. In vitro bactericidal effects of 405-nm and 470-nm blue light. Photomed. Laser Surg. 2006, 24, 684–688. [Google Scholar] [CrossRef]
- Murdoch, L.E.; McKenzie, K.; Maclean, M.; Macgregor, S.J.; Anderson, J.G. Lethal effects of high-intensity violet 405-nm light on Saccharomyces cerevisiae, Candida albicans, and on dormant and germinating spores of Aspergillus niger. Fungal. Biol. 2013, 117, 519–527. [Google Scholar] [CrossRef] [PubMed]
- Mori, M.; Hamamoto, A.; Takahashi, A.; Nakano, M.; Wakikawa, N.; Tachibana, S.; Ikhara, T.; Nakaya, Y.; Akutagawa, M.; Kinouchi, Y. Development of a new water sterilization device with a 365 nm UV-LED. Med. Biol. Eng. Comput. 2007, 45, 1237–1241. [Google Scholar] [CrossRef] [PubMed]
- Maclean, M.; MacGregor, S.J.; Anderson, J.G.; Woolsey, G. Inactivation of bacterial pathogens following exposure to light from a 405-nanometer light-emitting diode array. Appl. Environ. Microbiol. 2009, 75, 1932–1937. [Google Scholar] [CrossRef] [PubMed]
- Ghate, V.S.; Ng, K.S.; Zhou, W.; Yang, H.; Khoo, G.H.; Yoon, W.B.; Yuk, H.G. Antibacterial effect of light emitting diodes of visible wavelengths on selected foodborne pathogens at different illumination temperatures. Int. J. Food Microbiol. 2013, 166, 399–406. [Google Scholar] [CrossRef]
- Kim, M.J.; Miks-Krajnik, M.; Kumar, A.; Yuk, H.G. Inactivation by 405 ± 5 nm light emitting diode on Escherichia coli O157: H7, Salmonella Typhimurium, and Shigella sonnei under refrigerated condition might be due to the loss of membrane integrity. Food Control 2016, 59, 99–107. [Google Scholar] [CrossRef]
- ISO16000-17; Indoor Air-Part 17: Detection and Enumeration of Moulds-Culture-Based Method. International Organization for Standardization (ISO): Geneva, Switzerland, 2011.
- ISO16000-18; Indoor Air-Part 18: Detection and Enumeration of Moulds-Sampling by Impaction. International Organization for Standardization (ISO): Geneva, Switzerland, 2011.
- International Commission on Non-Ionizing Radiation Protection. Guidelines on limits of exposure to ultraviolet radiation of wavelengths between 180 nm and 400 nm (incoherent optical radiation). Health Phys. 2004, 87, 171–186. [Google Scholar] [CrossRef]
- Maclean, M.; McKenzie, K.; Anderson, J.G.; Gettinby, G.; MacGregor, S.J. 405 nm light technology for the inactivation of pathogens and its potential role for environmental disinfection and infection control. J. Hosp. Infect. 2014, 88, 1–11. [Google Scholar] [CrossRef]
- Lawrence, K.P.; Douki, T.; Sarkany, R.P.; Acker, S.; Herzog, B.; Young, A.R. The UV/visible radiation boundary region (385–405 nm) damages skin cells and induces “dark” cyclobutane pyrimidine dimers in human skin in vivo. Sci. Rep. 2018, 8, 12722. [Google Scholar] [CrossRef]










| Microorganism | Temperature, °C | LED Wavelength, nm | Distance from Petri Dish, cm | Irradiation Time, h | Dose | Source |
|---|---|---|---|---|---|---|
| Escherichia coli, Vibrio parahaemolyticus, Staphylococcus aureus, Salmonealla enterica | 4, 10, 20, 30, 40, 50 | 254, 365, 405 | 2 | 0.5 | 27 J/cm2 | [23] |
| S. aureus, Klebsiella pneumonia, Clotridium perfringerns, Acinetobacter aumannii, etc. (6) | 27 ±1 | 405 | 2 | 0.5, 1, 1.5, 2, 2.5, 3, 3.5, 4, 4.5, 5, 5.5, 6 | 10 mW/cm2 | [24] |
| E. coli, S. Typhimurium, Listeria monocytogenes, S. aureus | 10–15 | 461, 521, 642 | 4.5 | 7.5 | 22.1, 16, 25.4 mW/cm2 | [25] |
| E. coil, S. Typhimurium, Shigella sonnei | 4 ± 1 | 405 ± 5 | 4.5 | 7.5 | 18 mW/cm2 | [26] |
| L. monocytogenes | 4, 15, 25 | 405 | 4.5 | 8 | 26 ± 2 mW/cm2 | [18] |
| 275 nm | 370 nm | 385 nm | 405 nm | |
|---|---|---|---|---|
| Peak wavelength (nm) | 276.3 | 370.1 | 383.7 | 404.5 |
| Centroid wavelength (nm) | 277.1 | 372.7 | 385.6 | 405.7 |
| FWHM (full width at half maximum) | 12.81 | 9.58 | 12.07 | 12.65 |
| Intensity (W/m2) at 15 cm | 0.54 with quartz glass | 6.2 with petri dish cover | 18.4 with petri dish cover | 21.8 with petri dish cover |
| B. subtilis | E. coli | P. chrysogenum | C. cladosporidides | |
|---|---|---|---|---|
| 275 nm a | 30 s | 5 s | 60 s | 120 s |
| 60 s | 10 s | 180 s | 300 s | |
| 90 s | 20 s | 300 s | 480 s | |
| 120 s | 30 s | 420 s | 660 s | |
| 370 nm 385 nm 405 nm | 15 min a | 30 min b | ||
| 30 min a | 60 min b | |||
| 45 min b | 90 min c | |||
| 60 min c | 120 min c | |||
| Wavelength | 275 nm | 370 nm | 385 nm | 405 nm | |
|---|---|---|---|---|---|
| Irradiation Time | |||||
| Control case 0 s | ![]() | ![]() ![]() | |||
| CFU/mL | 40.5 | 55.5 | |||
| 275 nm: 30 s Other: 15 min | ![]() | ![]() | ![]() | ![]() | |
| CFU/mL | 26.5 | 37.75 | 34.5 | 38.88 | |
| 275 nm: 60 s Other: 30 min | ![]() | ![]() | ![]() | ![]() | |
| CFU/mL | 19.5 | 31 | 23 | 27.13 | |
| 275 nm: 90 s Other: 45 min | ![]() | ![]() | ![]() | ![]() | |
| CFU/mL | 15 | 21.33 | 16 | 19.5 | |
| 275 nm: 120 s Other: 60 min | ![]() | ![]() | ![]() | ![]() | |
| CFU/mL | 10.5 | 20 | 14 | 13 | |
| Wavelength | 275 nm | 370 nm | 385 nm | 405 nm | |
|---|---|---|---|---|---|
| Irradiation Time | |||||
| Control case 0 s | ![]() | ![]() ![]() | |||
| CFU/mL | 581 | 669 | |||
| 275 nm: 5 s Other: 15 min | ![]() | ![]() | ![]() | ![]() | |
| CFU/mL | 398.5 | 249.5 | 102.75 | 130.63 | |
| 275 nm: 10 s Other: 30 min | ![]() | ![]() | ![]() | ![]() | |
| CFU/mL | 293 | 54 | 11.25 | 13.38 | |
| 275 nm: 20 s Other: 45 min | ![]() | ![]() | ![]() | ![]() | |
| CFU/mL | 50.75 | 7 | 0.3 | 0.5 | |
| 275 nm: 30 s Other: 60 min | ![]() | ![]() | ![]() | ![]() | |
| CFU/mL | 9.75 | 2 | 0 | 0.5 | |
| Wavelength | 275 nm | 370 nm | 385 nm | 405 nm | |
|---|---|---|---|---|---|
| Irradiation Time | |||||
| Control case 0 s | ![]() | ![]() ![]() | |||
| CFU/mL | 41 | 18.67 | |||
| 275 nm: 1 min Other: 30 min | ![]() | ![]() | ![]() | ![]() | |
| CFU/mL | 32.3 | 15.67 | 18.67 | 16.83 | |
| 275 nm: 3 min Other: 60 min | ![]() | ![]() | ![]() | ![]() | |
| CFU/mL | 19 | 12 | 13 | 11.67 | |
| 275 nm: 5 min Other: 90 min | ![]() | ![]() | ![]() | ![]() | |
| CFU/mL | 9 | 10 | 10.5 | 9.5 | |
| 275 nm: 7 min Other: 120 min | ![]() | ![]() | ![]() | ![]() | |
| CFU/mL | 0.8 | 9 | 9.5 | 9.3 | |
| Wavelength | 275 nm | 370 nm | 385 nm | 405 nm | |
|---|---|---|---|---|---|
| Irradiation Time | |||||
| Control case 0 s | ![]() | ![]() ![]() | |||
| CFU/mL | 100.5 | 99.5 | |||
| 275 nm: 2 min Other: 30 min | ![]() | ![]() | ![]() | ![]() | |
| CFU/mL | 81.25 | 88.67 | 87 | 86.83 | |
| 275 nm: 5 min Other: 60 min | ![]() | ![]() | ![]() | ![]() | |
| CFU/mL | 28.5 | 79.33 | 74 | 70.5 | |
| 275 nm: 8 min Other: 90 min | ![]() | ![]() | ![]() | ![]() | |
| CFU/mL | 6.75 | 59 | 60.5 | 61.5 | |
| 275 nm: 11 min Other: 120 min | ![]() | ![]() | ![]() | ![]() | |
| CFU/mL | 1 | 44.5 | 48.5 | 50.5 | |
Publisher’s Note: MDPI stays neutral with regard to jurisdictional claims in published maps and institutional affiliations. |
© 2022 by the authors. Licensee MDPI, Basel, Switzerland. This article is an open access article distributed under the terms and conditions of the Creative Commons Attribution (CC BY) license (https://creativecommons.org/licenses/by/4.0/).
Share and Cite
Bang, J.-I.; Kim, J.-H.; Choi, A.; Sung, M. The Wavelength-Based Inactivation Effects of a Light-Emitting Diode Module on Indoor Microorganisms. Int. J. Environ. Res. Public Health 2022, 19, 9659. https://doi.org/10.3390/ijerph19159659
Bang J-I, Kim J-H, Choi A, Sung M. The Wavelength-Based Inactivation Effects of a Light-Emitting Diode Module on Indoor Microorganisms. International Journal of Environmental Research and Public Health. 2022; 19(15):9659. https://doi.org/10.3390/ijerph19159659
Chicago/Turabian StyleBang, Jong-Il, Ji-Hi Kim, Anseop Choi, and Minki Sung. 2022. "The Wavelength-Based Inactivation Effects of a Light-Emitting Diode Module on Indoor Microorganisms" International Journal of Environmental Research and Public Health 19, no. 15: 9659. https://doi.org/10.3390/ijerph19159659
APA StyleBang, J.-I., Kim, J.-H., Choi, A., & Sung, M. (2022). The Wavelength-Based Inactivation Effects of a Light-Emitting Diode Module on Indoor Microorganisms. International Journal of Environmental Research and Public Health, 19(15), 9659. https://doi.org/10.3390/ijerph19159659